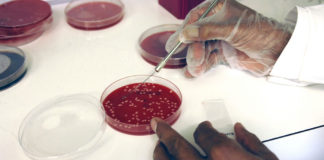
Por primera vez crean Sangre en un Laboratorio

Etiqueta: Revista Nature
Una investigación permite hacer más efectiva la vacuna contra la Tuberculosis
La tuberculosis es una de las diez principales causas de muerte en el mundo causada por un solo agente infeccioso. Aunque existe una vacuna...
Según estudio los videojuegos ayudarían a mejorar la habilidad cognitiva
Una revista científica ha publicado un estudio en el que se arrojan pruebas de que los videojuegos ayudan a mejorar las habilidades cognitivas y...
Científicos descubren que la Serotonina es capaz de acelerar el Aprendizaje
Un equipo internacional de científicos ha descubierto que la serotonina es capaz de acelerar el aprendizaje en ratones, según revela un estudio publicado por...
Científicos desarrollan unos Fotorreceptores artificiales que devuelven visión a ratones ciegos
Un grupo de científicos de la universidad Fudan de Shanghai (China) ha desarrollado unos fotorreceptores artificiales que devolvieron la visión a ratones ciegos, lo...
Estudio revela la existencia de proceso biológico para mejorar respuesta al...
Científicos en Estados Unidos han identificado un nuevo proceso biológico capaz de mejorar la resistencia al cáncer de nuestro sistema inmunológico, según un estudio...
Crean sensor electrónico para controlar el estado de salud
Un grupo de científicos japoneses de la Universidad de Tokio ha inventado un sensor electrónico que se puede adherir a la piel cómodamente para...
Por primera vez crean Sangre en un Laboratorio
Investigadores del Hospital de Niños de Boston y del centro Weill Cornell Medicine (ambos en EE.UU.) han conseguido obtener por primera vez células madre...
Crean prótesis de brazo que detecta señales de médula espinal
Un grupo de científicos ha desarrollado una tecnología que permite a prótesis de brazos detectar señales procedentes de nervios de la médula espinal, según...
Estudio establece el límite biológico de la vida humana
El ser humano ha llegado al límite de su esperanza de vida, según un informe publicado por la revista Nature, bajo el título “Evidencia...
Logran reducir proteína clave del Alzheimer
Científicos de la Universidad de Zúrich lograron reducir una proteína clave para el alzheimer mediante una terapia experimental.
El hallazgo -publicado en la revista Nature-...
Nuevo paso hacia una vacuna universal contra el cáncer
Científicos alemanes han dado un paso adelante para crear una vacuna universal contra el cáncer gracias a una técnica que instruye al sistema inmune...
Desarrollan tratamiento para alargar la vida de órganos trasplantados
Científicos en Estados Unidos han desarrollado un tratamiento que alarga la esperanza de vida de animales con órganos trasplantados de otras especies, revela un...
Desarrollan medicamento que genera nanopartículas para curar el Cáncer
Científicos estadounidenses han creado un medicamento inyectable que genera nanopartículas capaces de facilitar la cura de la metástasis de tumores en el pulmón e...
Utilizan células madre para regenerar ojos con cataratas
Las terapias basadas en células madre han demostrado ser efectivas para regenerar el tejido ocular en niños con cataratas y reparar la córnea en...
Mecanismo celular que crea resistencia a los antibióticos
Científicos de la Universidad Británica de East Anglia describen en un estudio publicado en la revista Nature el funcionamiento de una membrana celular que...
Verduras de hoja verde promueven la salud intestinal
Un equipo de investigadores de Melbourne y el Reino Unido ha descubierto que las verduras de hoja verde son esenciales para proteger la flora...
Científicos estudian anticuerpos para crear una vacuna contra la Malaria
Encontrar los anticuerpos que sean capaces de combatir la malaria podría ser útil a la hora de diseñar una vacuna contra esta enfermedad, según...
Descubren una Molécula que elimina la Proteína vinculada al Alzhéimer
Científicos en Corea del Sur han descubierto una molécula que podría eliminar las proteínas que se cree que contribuyen al desarrollo del alzhéimer, según...
Desarrollan Cámara que detecta objetos Ocultos a la vista
Científicos de la Universidad de Heriot-Watt en Edimburgo (Escocia) han diseñado una cámara que puede localizar con precisión la posición de objetos ocultos tras...
Cada vez más cerca de fabricar Riñones a partir de Células...
Científicos australianos han fabricado estructuras similares a las de un riñón humano embrionario a partir de células madre cultivadas en laboratorio, según publicó la...
Descubren una Molécula con implicaciones en el desarrollo del Alzheimer
Investigadores franceses y alemanes han detectado un nuevo péptido activo, un tipo de molécula formada por la unión de varios aminoácidos, con implicaciones en...
Inventan un Revolucionario Motor que funciona con Vapor de Agua
Bioingenieros de la Universidad Columbia, Nueva York, inventan el primer motor del mundo que funciona con la energía creada en el proceso de evaporación...
Se dieron importantes Aportes Científicos durante la II Expotesis UCV
Según la Revista Nature, el Perú se sitúa como el sexto país a nivel de Sudamérica en cuanto a publicación de artículos científicos, antecedido...